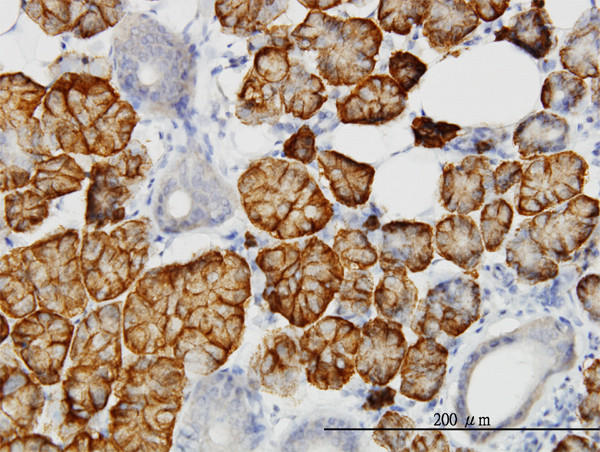
LLGL2 Antibody in Immunohistochemistry (Paraffin) (IHC (P))

Search
Abnova
LLGL2 Monoclonal Antibody (4G2)
{{$productOrderCtrl.translations['antibody.pdp.commerceCard.promotion.promotions']}}
{{$productOrderCtrl.translations['antibody.pdp.commerceCard.promotion.viewpromo']}}
{{$productOrderCtrl.translations['antibody.pdp.commerceCard.promotion.promocode']}}: {{promo.promoCode}} {{promo.promoTitle}} {{promo.promoDescription}}. {{$productOrderCtrl.translations['antibody.pdp.commerceCard.promotion.learnmore']}}
产品信息
H00003993-M06
种属反应
宿主/亚型
分类
类型
克隆号
抗原
偶联物
形式
浓度
规格
纯化类型
保存液
内含物
保存条件
运输条件
产品详细信息
Sequence of this protein is as follows: SLKVKGGASE LQEDESFTLR GPPGAAPSAT QITVVLPHSS CELLYLGTES GNVFVVQLPA FRALEDRTIS SDAVLQRLPE EARHRRVFEM VEALQEHPR
靶标信息
LLGL1 is a protein that is similar to a tumor suppressor in Drosophila. The protein is part of a cytoskeletal network and is associated with nonmuscle myosin II heavy chain and a kinase that specifically phosphorylates this protein at serine residues. The gene for LLGL1 is located within the Smith-Magenis syndrome region on chromosome 17. LLGL2 is a protein similar to lethal (2) giant larvae of Drosophila. In fly, the protein's ability to localize cell fate determinants is regulated by the atypical protein kinase C (aPKC). In human, this protein interacts with aPKC-containing complexes and is cortically localized in mitotic cells.
仅用于科研。不用于诊断过程。未经明确授权不得转售。
篇参考文献 (0)
生物信息学
蛋白别名: HGL; human giant larvae homolog; lethal giant larvae homolog 2, scribble cell polarity complex component; Lethal(2) giant larvae protein homolog 2; LLGL scribble cell polarity complex component 2; LLGL2, scribble cell polarity complex component; unnamed protein product
基因别名: HGL; Hugl-2; LGL2; LLGL2
UniProt ID: (Human) Q6P1M3
Entrez Gene ID: (Human) 3993